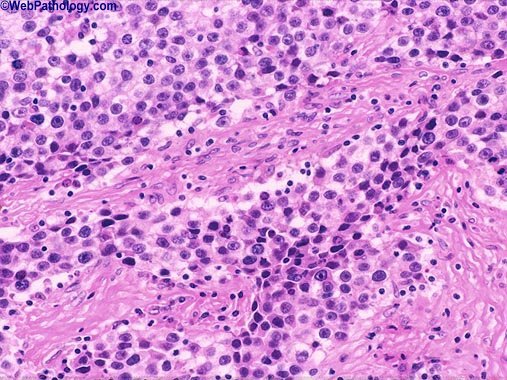
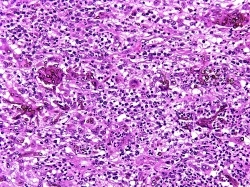

Treatment of postmenopausal women with systemic conjugated estrogens has demonstrated:
1 Increased cellular atypia
2 Decreased mitotic activity of keratinocytes
3 Increased dermal collagen content
4 Decreased sebaceous gland activity
5 Increased skin laxity

Increased dermal collagen content
Systemic use of conjugated estrogens in postmenopausal women increases total skin thickness, dermal collagen content and mitotic activity of keratinocytes. In addition, there is a reduction of dry skin, slackness and increased hydration.

Osteoclast-like giant cells are characteristic of:
1 Giant cell fibroblastoma
2 Reticulohistiocytoma
3 Necrobiosis lipoidica diabeticorum
4 Giant cell tumor of the tendon sheath
5 Necrobiotic xanthogranuloma

Giant cell tumor of the tendon sheath
Osteoclast-like giant cells are seen in giant cell tumor of the tendon sheath. Osteoclast-like giant cells have eosinophilic cytoplasm with haphazardly arranged nuclei. Reticulohistiocytoma is characterized by giant cells with an oncocytic glassy pink cytoplasm.

This biopsy was obtained from an annular pigmented plaque on the trunk, what is this neoplasm?
1 Targetoid hemosiderotic hemangioma
2 Glomeruloid hemangioma
3 Angiosarcoma
4 Kaposi’s sarcoma
5 Tufted hemangioma

Targetoid hemosiderotic hemangioma
Targetoid Hemosiderotic Hemangioma: Occurs most commonly on young adult males on the trunk and named for its clinical appearance. The lesion typically appears as a plaque with concentric rings, there is violaceous central region surrounded by a ring of pallor which is then surrounded by an erythematous or brown rim. Histologically in the superficial dermis there are dilated blood vessels, some of which have plump hobnailed endothelial cells. In the deeper dermis the vessels have a narrower lumen and dissect between the collagen bundles. Often within the lesion there are extravasated red blood cells and hemosiderin.
Target Sign

The pigment deposits in ochronosis are accentuated with:
1 Cresyl violet
2 Methyl-green pyronin
3 Silver nitrate
4 Bodian
5 Cresyl violet and silver nitrate

Cresyl violet
Cresyl violet stains the pigment deposits in ochronosis black. Methylene blue will also stain the pigment black. This pigment does not stain with silver nitrate. The Bodian stain is for nerves. Methyl-green pyronin stains RNA and DNA.
Crysel violet ear ring hook on bananas!

This presented as a papule with a tuft of hair on the face, what is this neoplasm?
1 Trichofolliculoma
2 Trichoepithelioma
3 Fibrous Papule
4 Acrochordon
5 Fibrofolliculoma

Trichofolliculoma
Trichofolliculoma: Most often occurs on the face as a papule with a tuft of hair. Histologically composed of a central dilated large follicle (Mama hair), from which many secondary smaller hair follicles radiate (Baby hairs), with the entire unit often enveloped in a vascularized fibrotic stroma. If sebaceous glands are associated with the hair follicles then the term used is a sebaceous trichofolliculoma or a Folliculosebaceous cystic hamartoma. Within the mesenchymal stroma there are increased CD34 and factor XIIIA fibroblasts and Merkel cells as is seen in the ORS of the follicles.

Psoriasis has been shown to be genetically linked to:
1 Pityriasis rubra pilaris
2 Clear cell acanthomas
3 Epidermodysplasia verruciformis
4 Verruciform xanthomas
5 Poromas

Epidermodysplasia verruciformis
Mutations have been found in the EVER1 and EVER2 genes in epidermodysplasia verruciformis; these genes are on 17q25, the location of the PSORS2 gene (one of the genes implicated in the inheritance of psoriasis).

Multiple pilomatricomas are seen in:
1 Myotonic dystrophy
2 Cowden’s
3 Turner’s
4 Gorlin’s
5 Myotonic dystrophy and Turner’s

Myotonic dystrophy and Turner’s
Multiple pilomatricomas are seen in Rubinstein-Taybi, Gardner’s (cyst-like pilomatricomas), myotonic dystrophy, Turner’s, sarcoidosis, sternal cleft and coagulation defects.
Tina Turner & Hawaii Ironman Super Dad & Son

All of the following markers can be helpful in differentiating basal cell carcinoma from trichoepithelioma except
1 CD10
2 CD31
3 CD34
4 Bcl-2
5 Stromelysin-3
Diffuse staining with this marker is suggestive of BCC rather than trichoepithelioma:
1 CAM 5.2
2 Bcl-2
3 PTAH
4 CEA
5 Cytokeratin 8
Bcl-2
Trichoepitheliomas stain with bcl-2 on the periphery of individual tumor islands.
BCL connector
Diffuse = BCC
PERIPHERAL = Trichoepithelomas

Clinically, a nondescript hyperkeratotic papule on the ulnar side of the base of the fifth finger is most likely:
1 Acquired digital fibrokeratoma
2 Accessory digit
3 Cutaneous horn
4 Digital fibromatosis
5 Glomus tumor

Accessory digit Accessory digits (supernumerary digits) are usually found at the base of the fifth finger, often bilaterally.

Cicatricial pemphigoid antibodies directed against this are associated with high frequency of malignancy:
1 Laminin 5
2 Laminin 6
3 Beta4-integrin
4 BPAg2
5 All of these answers are correct

Laminin 5
Anti-laminin 5 cicatricial pemphigoid (CP) is also known as anti-epiligrin CP. Anti-epiligrin CP is associated with an increased frequency of internal adenocarcinomas. Laminin 5 is composed of three chains (heterotrimer), alpha3, beta3, gamma2. Antibodies are frequently directed against the alpha3 chain, and so cross-reactivity can be observed with laminin 6, as laminin 6 (alpha3beta1gamma1) has the alpha3 chain as well. Beta4-integrin antibodies have been associated with ocular CP. BPAg2 antibodies are seen in CP patients that have mucosal as well as skin disease.

What is this neoplasm?
1 Sclerotic fibroma
2 Angiofibroma
3 Keloid
4 Neurofibroma
5 Dermatofibroma

Sclerotic fibroma Sclerotic Fibroma (circumscribed storiform collagenoma): This can occur as an isolated lesion n the head or neck or upper extremities, but multiple lesions are associated with Cowden's disease which is an AD disorder linked to a mutation of PTEN on chromosome 10p. Histology: Dome shaped papule with an overlying attenuated epidermis. A well-circumscribed nodule composed of thickened homogenous collagen that is arranged in whorls with a thumbprint or grains of wood appearance is seen in the dermis. Overall the lesion exhibits low cellularity and the elastic fibers are absent. The tumor stains positively with vimentin, Factor XIIIA and focally for CD34.
What is this neoplasm?
1 Trichoadenoma
2 Trichoblastoma
3 Trichoepithelioma
4 Basal cell carcinoma
5 Nevus comedonicus

Trichoadenoma
Trichoadenoma: A nodule on the face or butt that is slightly depressed. Typically confined to the upper dermis and composed of multiple milia or infundibular-like cysts that have a squamous epithelial lining associated with a granular layer and central flakey keratin in the lumen. The stroma can be sclerotic. The lesion is composed primary of cysts with a few thin strands of basaloid cells; if basaloid strands predominate with only a few cysts then lesion is a trichoepithelioma.
John Lennon Glasses

Which of the following body contains calcium:
1 Negri body
2 Lipschutz body
3 Michaelis-Gutman body
4 Guarnieri body
5 Negri body and Michaelis-Gutman body

Michaelis-Gutman body
The Michaelis-Gutman body is a concentrically laminated spherical inclusion that contains calcium that is seen within macrophages in malakoplakia. Other inclusion bodies that contain calcium are Schaumann bodies and psammoma bodies. The Negri body is seen in rabies. The Lipschutz body is an intranuclear inclusion seen in herpes. It is considered synonymous with the Cowdry A body. The Guarnieri body is seen in smallpox.
FIG CODE:
BIG MAC = Macrophage
Cow = Calcium
George Michael Wham = Michaelis-Gutman Malakoplakia
Malakoplakia is a rare inflammatory condition which makes its presence known as a papule, plaque[disambiguation needed] or ulceration that usually affects the genitourinary tract.[1]:274 However, it may also be associated with other bodily organs. It was initially described in the early 1900s as soft yellowish plaques found on the mucosa of the urinary bladder. Microscopically it is characterized by the presence of foamy histiocytes with basophilic inclusions called Michaelis-Gutmann bodies.
It usually involves gram negative bacteria.[2]
Malakoplakia is thought to result from the insufficient killing of bacteria by macrophages. Therefore, the partially digested bacteria accumulate in macrophages and leads to a deposition of iron and calcium. The impairment of bactericidal activity manifests itself as the formation of an ulcer, plaque or papule.
Malakoplakia is associated with patients with a history of immunosuppression due to lymphoma, diabetes mellitus, renal transplantation, or because of long-term therapy with systemic corticosteroids.
Treatment
Today, antibiotics are used for treatment of malakoplakia.

This keratin is associated with hair and nail:
1 Keratin 6
2 Keratin 8
3 Keratin 10
4 Keratin 16
5 Keratin 17
Keratin 17
Keratins 6 and 16 are found in the nail. Keratin 17 is seen in the nail as well as in the hair follicle, and patients with pachyonychia congenital type 2, in which there is a mutation of keratins 6b and 17, have nail findings as well as steatocysts.

Subcutaneous panniculitis-like T-cell lymphoma with an indolent course is positive for which of the following?
1 CD4
2 CD8
3 CD10
4 CD45
5 CD57

CD8
There seems to be two subsets of subcutaneous panniculitis-like T-cell lymphoma. One has an indolent course, and is often CD8-positive and is positive for the alpha-beta T-cell receptor. The other has an aggressive course, sometimes with evidence of systemic hemophagocytosis and high mortality. This subset is CD56-positive and positive for the gamma-delta T-cell receptor.

Histologic examination of cutaneous metastases from breast cancer is likely to demonstrate:
1 Dense lymphocytic infiltration
2 Tumors cells perivascularly
3 Eosinophilia
4 Tumor cells in the lymphatics
5 Band-like dermal infiltrate
Tumor cells in the lymphatics
Histologic appearance of metastatic breast carcinoma to the skin typically shows tumor cells in linear arrangement in so-called “Indian-filing” pattern. These tend to occur in the dermis and subcutaneous lymphatics. Extensive lymphatic dissemination may be caused by retrograde lymphatic spread. The tumor cells are large, pleomorphic with hyperchromatic nuclei.

This is an H and E stained slide, what is the organism?
1 Exophiala jeanselmei
2 Chromomycosis
3 Nocardia
4 Zygomycosis
5 Mucormycosis
Exophiala jeanselmei
Phaeohyphomycotic cyst: Typically the result of an opportunist infection caused by being impaled by a splinter contaminated with a dematiaceous or pigmented fungus. Most commonly seen on distal extremities and results in a dermal abscess with fibrous tissue and granulomas within which are pigmented hyphae and yeast. The most common organism is Exophiala jeanselmei (yellow-brown septae hypha) and Wangiella dermatitidis. Histology: Circumscribed cyst with a fibrous wall within which is a chronic granulomatous reaction or dermal abscess, a splinter is sometimes seen along with the brown filamentous hyphae and yeast.
Phaeohyphomycosis
Description:
A mycotic infection of humans and lower animals caused by a number of dematiaceous (brown-pigmented) fungi where the tissue morphology of the causative organism is mycelial. This separates it from other clinical types of disease involving brown-pigmented fungi where the tissue morphology of the organism is a grain (mycotic mycetoma) or sclerotic body (chromoblastomycosis). The etiological agents include various dematiaceous hyphomycetes especially species of Exophiala, Phialophora, Wangiella, Bipolaris, Exserohilum, Cladophialophora , Phaeoannellomyces, Aureobasidium, Cladosporium, Curvularia and Alternaria. Ajello (1986) listed 71 species from 39 genera as causative agents of phaeohyphomycosis.
Clinical manifestations:
Clinical forms of phaeohyphomycosis range from localized superficial infections of the stratum corneum (tinea nigra) to subcutaneous cysts (phaeomycotic cyst) to invasion of the brain. Ideally, individual disease states involving an invasive fungal infection by a dematiaceous hyphomycete should be designated by a specific description of the pathology and the causative fungal genus or species (where known); for example “pathology A” caused by “fungus X”.
- Subcutaneous phaeohyphomycosis:
Subcutaneous infections occur worldwide, usually following the traumatic implantation of fungal elements from contaminated soil, thorns or wood splinters. Exophiala jeanselmei and Wangiella dermatitidisare the most common agents and cystic lesions occur most often in adults. Occasionally, overlying verrucous lesions are formed, especially in the immunosuppressed patient.

The promontory sign is seen in:
1 Tufted angioma
2 Glomeruloid hemangioma
3 Spindle cell hemangioendothelioma
4 Acroangiodermatitis of Mali
5 Kaposi’s sarcoma

Kaposi’s sarcoma
The promontory sign refers to the formation of new vessels around existing vessels and adnexal structures. This is seen in Kaposi’s.

What is the best diagnosis?
1 Psoriasiform
2 Dermatitis Herpetiformis
3 Angiolymphoid Hyperplasia with Eosinophilia
4 Lichen Nitidus
5 Ochronosis

Angiolymphoid Hyperplasia with Eosinophilia
Angiolymphoid Hyperplasia with Eosinophilia(EPITHELIOID HEMANGIOMA) consists of solitary or multiple benign cutaneous nodules comprised of immature and mature vascular structures intermingled with endothelial cells and a varied infiltrate of eosinophils, histiocytes, lymphocytes, and mast cells.
The most common cause of a longitudinal groove of the nail plate is:
1 Myxoid cyst
2 Verruca vulgaris
3 Psoriasis
4 Onychomycosis
5 Paronychia
Myxoid cyst
A myxoid cyst is not a true cyst as it is devoid of cyst lining. They usually occur in an acral location and are the most common cause of a longitudinal groove of a nail plate.

The deficiency in familial multiple cutaneous leiomyomatosis is:
1 Arginase
2 Adenosine deaminase
3 Endoglin
4 MC1R
5 Fumarate hydratase
Fumarate hydratase
Fumarate hydratase is deficient in familial multiple cutaneous leiomyomatosis. This same enzyme is deficient in familial uterine leiomyomatosis associated with renal cell cancer. Arginase is deficient in arginemia. Adenosine deaminase is deficient in autosomal recessive severe combined immunodeficiency disease (SCID). Endoglin is deficient in some patients with Osler-Weber-Rendu. MC1R (melanocortin 1 receptor) shows sequence variation in people with red hair.

Psoriasis vulgaris may demonstrate all except one of the following histopathologic changes.
1 Munro microabscesses
2 Clubbing of the rete ridges
3 Spongiform pustules of Kogoj
4 Hypergranulosis
5 Suprapapillary thinning
Hypergranulosis
Histopathological features of psoriasis: Hyperkeratosis with confluent parakertosis associated with a thin to absent granular layer, Uniform elongation of rete ridges and they are expanded at their tips (Clubbing of rete ridges), papillary dermal edema with dilated toruous capillaries, thinned suprapapillary plates, neutrophils within stratum corneum (Munro’s micorabscesses), neutrophils within the spinous layer (spongiform pustule of Kogoj), and superficial perivascular lymphocytic infiltrate.

Which marker helps to differentiate extranodal NK-T cell lymphoma from cutaneous gamma delta lymphoma?
1 CD56
2 MUM-1
3 EBV status
4 CD43
5 bcl-2
EBV status
Both cutaneous gamma delta lymphoma and extranodal NK-T cell lymphoma are CD56+. However, only extranodal NK-T cell lymphoma is EBV + while cutaneous gamma delta lymphoma is EBV negative. Both these lymphomas have a 5-year survival rate that approaches 0%.









